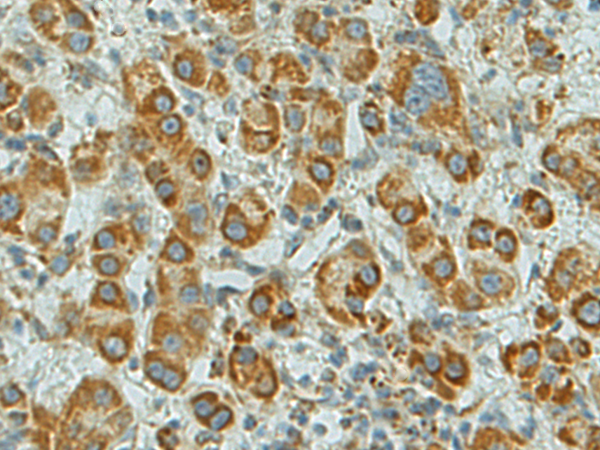

中文名稱(chēng): 兔抗SFTPA1多克隆抗體
英文名稱(chēng): Anti-SFTPA1 rabbit polyclonal antibody
別 名: surfactant protein A1; SPA; PSAP; PSPA; SP-A; SPA1; PSP-A; SFTP1; SP-A1; COLEC4; SFTPA1B
相關(guān)類(lèi)別: 一抗
儲(chǔ) 存: 冷凍(-20℃)
宿 主: Rabbit
抗 原: SFTPA1
反應(yīng)種屬: Human
標(biāo) 記 物: Unconjugate
克隆類(lèi)型: rabbit polyclonal
技術(shù)規(guī)格
|
Background: |
This gene encodes a lung surfactant protein that is a member of a subfamily of C-type lectins called collectins. The encoded protein binds specific carbohydrate moieties found on lipids and on the surface of microorganisms. This protein plays an essential role in surfactant homeostasis and in the defense against respiratory pathogens. Mutations in this gene are associated with idiopathic pulmonary fibrosis. Alternate splicing results in multiple transcript variants. |
|
Applications: |
ELISA, IHC |
|
Name of antibody: |
SFTPA1 |
|
Immunogen: |
Fusion protein of human SFTPA1 |
|
Full name: |
surfactant protein A1 |
|
Synonyms: |
SPA; PSAP; PSPA; SP-A; SPA1; PSP-A; SFTP1; SP-A1; COLEC4; SFTPA1B |
|
SwissProt: |
Q8IWL2 |
|
ELISA Recommended dilution: |
5000-10000 |
|
IHC positive control: |
Human liver cancer |
|
IHC Recommend dilution: |
150-300 |
購(gòu)物車(chē)
幫助
021-54845833/15800441009
